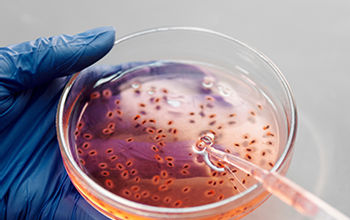

Rhaglen o ddarlithoedd rhagflas, gweminarau a diwrnodau agored rhithwir yw ein cyfres o weminarau ‘Cychwyn Arni/Da’. Bwriad y rhaglen yw cynnig rhagflas ichi ar y gwahanol bynciau y byddwch chi’n eu hastudio gyda ni.
Eich cyfle chi yw’r rhaglen hon, y bydd darlithwyr a fydd yn addysgu ar eich gradd yn ei chyflenwi, i weld sut beth yw bod yn fyfyriwr ar hyn o bryd.
Rydyn bellach wedi cwblhau ein cyfres o weminarau 'Cychwyn Arni/Da' ar gyfer 2021 - diolch i pawb a ymunodd a ni ar gyfer ein darlithoedd blasu pwnc, seminarau a sesiynau holi ac ateb.
Gallwch ddal i fyny ar ein holl sesiynau gweminar isod.